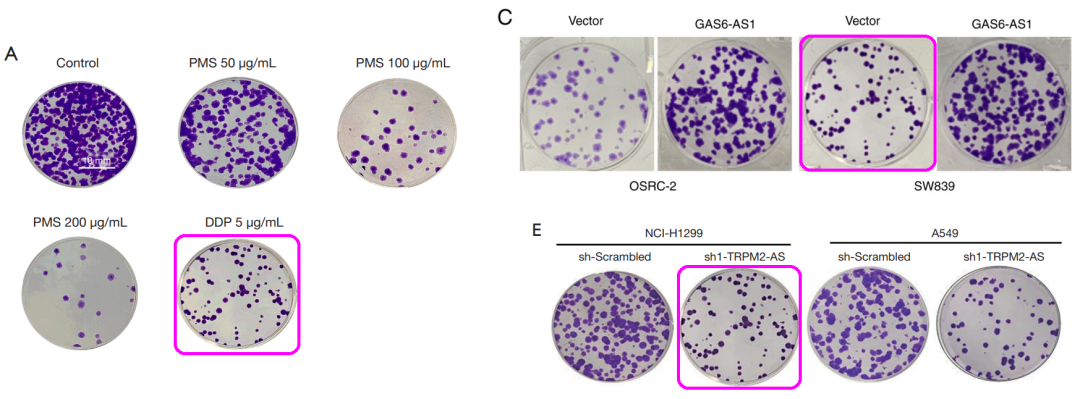
作者不回应期刊社,天津医科大学第二医院李荣等人onco

p38蛋白

tyrosine phosphatase)家族成员之一,也称酪氨酸蛋白磷酸酶非受体型6
图片尺寸595x759
hepatology丨中国学者揭示肝脂肪变性新机制
图片尺寸665x449
这家医院与多篇已发表论文图片重复导致文章被撤回
图片尺寸660x344
大瓜哈佛教授被抓学术不端把样品重复使用2篇顶刊已经被撤稿
图片尺寸680x296
mapk主要有4个亚族,对应4条mapk通路:erk,p38,jnk,bmk1(erk5).
图片尺寸1080x1256
邹云增压力超负荷下心肌纤维化调节机制的新发现β2微球蛋白的作用
图片尺寸689x441
图片存在重复四川省人民医院的论文被评议
图片尺寸660x686
作者不回应期刊社,天津医科大学第二医院李荣等人onco
图片尺寸1080x399
prl-3通过抑制p38mapk通路促肿瘤适应缺氧微环境本研究由浙江大学基础
图片尺寸660x566
显示,结合型次级12羟胆汁酸比结合型初级12羟胆汁酸对erk1/2 和 p38
图片尺寸1100x776
对传统蛋白的正/负调控,如胚胎发育(toddler),肌肉功能(mln,dworf
图片尺寸700x591
冷刺激对骨髓间充质干细胞增殖及成骨分化的影响
图片尺寸1080x1243
应力通过连接蛋白43(cx43)和erk1/2信号通路增强小鼠ipscs的成骨分化
图片尺寸660x674
通过gαi/ o-gβγ-rhoa / rock1-p38信号级联促进脂肪褐变和脂肪分解
图片尺寸633x447
应力通过连接蛋白43(cx43)和erk1/2信号通路增强小鼠ipscs的成骨分化
图片尺寸660x463
综述甘波谊团队slc7a11与肿瘤铁死亡
图片尺寸371x380
nod样受体家族,识别与微生物相关的肽聚糖,并通过激活下游nf-kb和p38
图片尺寸660x541
连接蛋白和mrna水平的比较yqtlf治疗12周后显著抑制视网膜prc 2/p38
图片尺寸1055x1374
网药实验发q2区毕业特选紫苏叶的抗哮喘作用与mapk信号通路有关
图片尺寸554x412
il-17a诱导erk1/2磷酸化,p38 mapk和stat3(il-6-stat3)信号通路的激活
图片尺寸815x562